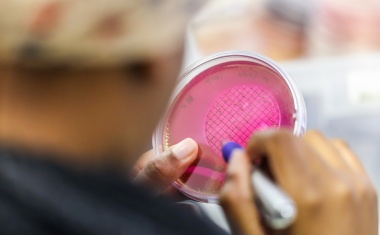
Photo
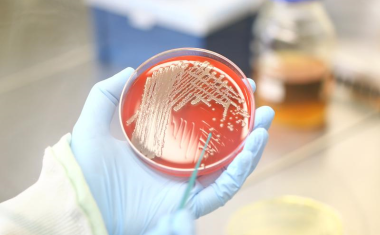
Photo

Forschung gegen Infektionen
Die Universitätsmedizin Magdeburg ist das erste deutsche Studienzentrum, das Patienten in die weltweit größte klinische Studie zur Staphylococcus aureus-Bakteriämie (SAB) aufnimmt.

Die Universitätsmedizin Magdeburg ist das erste deutsche Studienzentrum, das Patienten in die weltweit größte klinische Studie zur Staphylococcus aureus-Bakteriämie (SAB) aufnimmt.

Eine Studie zeigt individuelle Unterschiede in der Immunantwort der Nase. Forschende der Universität Tübingen geben neue Einblicke in die spezifische Antikörper-Reaktion von körpereigenem Immunglobulin A.

InfectoGnostics-Forscher haben einen Test entwickelt, mit dem sich genetische Eigenschaften des Bakteriums Staphylococcus aureus erkennen und mehr als 700 Stämme dieses Erregers unterscheiden lassen.

Auch ohne Resistenz können Bakterien eine Antibiotikabehandlung überstehen.

HZI-Verbundprojekt erhält Fördermittel von CARB-X, um bessere Medikamente gegen bakterielle Lungenentzündungen zu entwickeln.

Verschiedene Haftmechanismen von Bakterien wurden nun grundlegend verstanden.